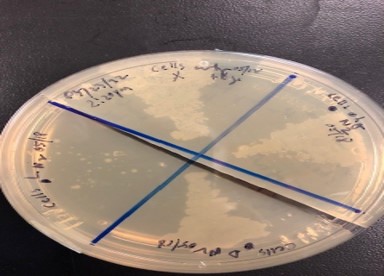
Petri Plate

Glove Box
Provides inert atmosphere to work with water- and air-sensitive compounds

Wet Glove Box
Provides inert atmosphere for solution phase reactions that involve water or wet solvent

Schlenk line
Manipulation of moisture and air-sensitive molecules via vacuum pump and argon line atmosphere